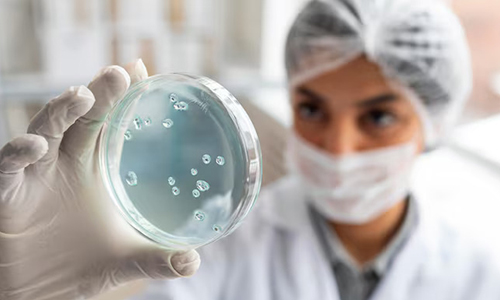
Breakthrough Results in Microbial Strain Engineering

Diagnostic Reagents & Kits (In Development)
IL-6 antigens and antibodies, prototype ELISA kits for inflammatory & hormonal biomarkers, and Lateral Flow Assays (LFA) for point-of-care diagnostics. Key differentiator: Rapid biomanufacturing using Vibrio natriegens.